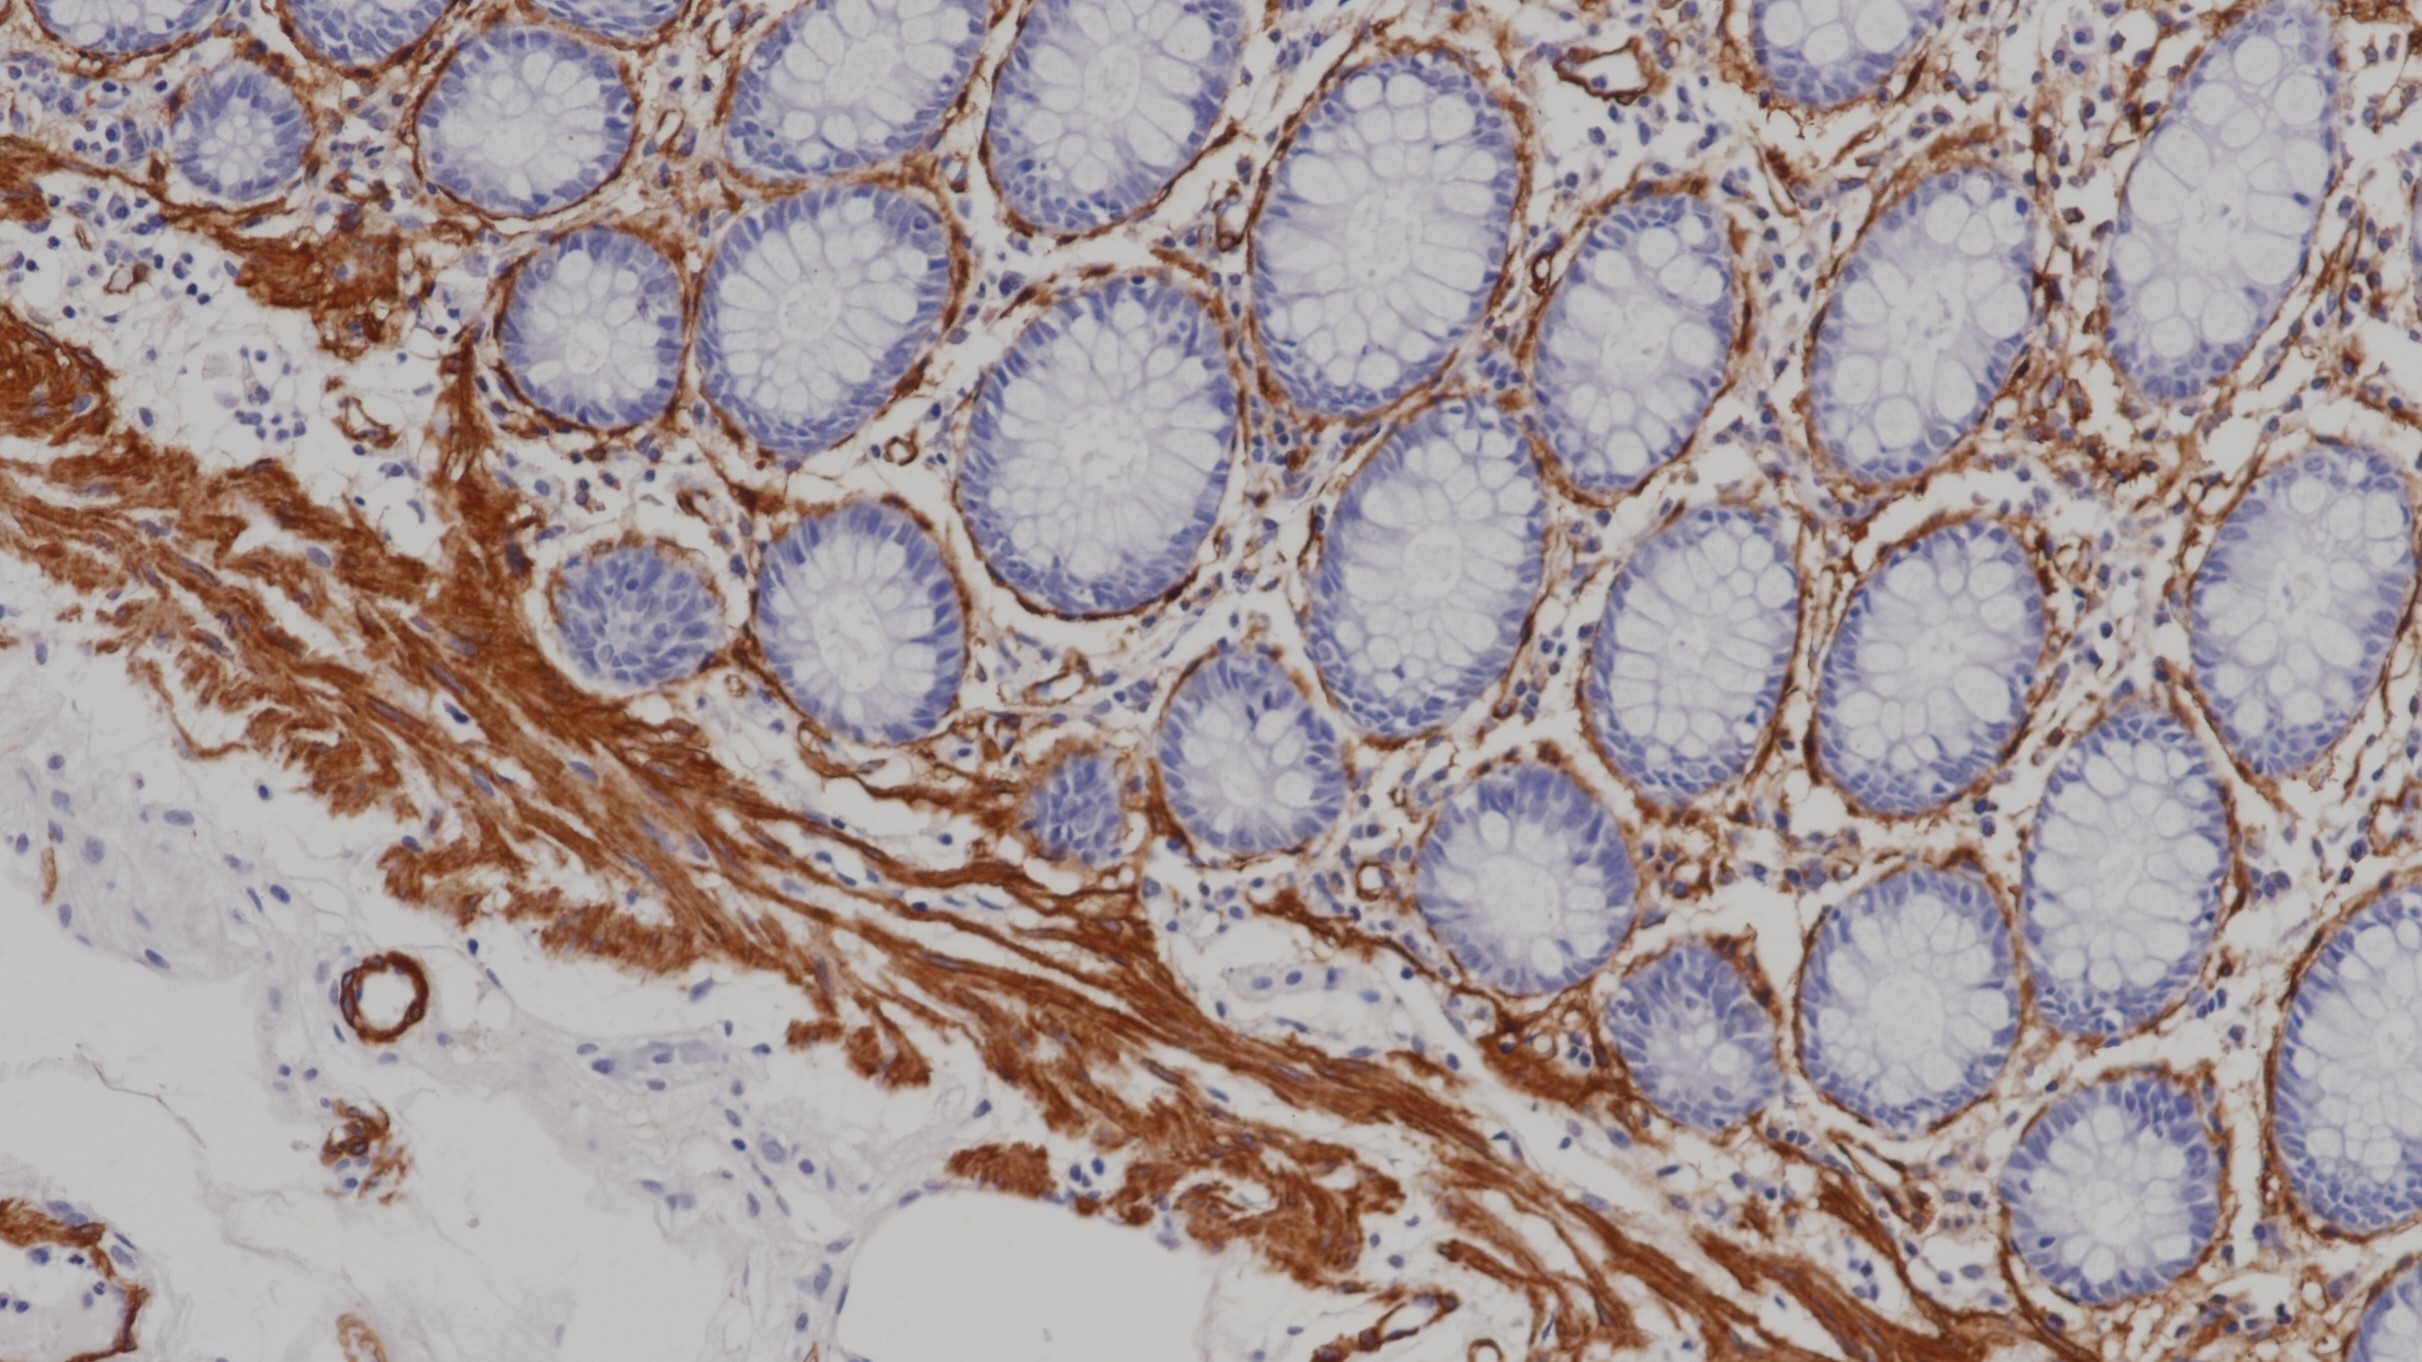
结肠SMA(1A4)染色

1.Raman Subhasri,Sherlin Herald J. Utility of smooth muscle actin and CD117 as reliable markers in the diagnosis of salivary gland neoplasms.[J]. Journal of oral and maxillofacial pathology : JOMFP,2019,23(2).
2.Li Ting,He Mingyuan,Li Zhonghao,Wang Dejiang,Xu Yingyi,Wu Wei,Yan Yi. [Metformin inhibits aortic atherosclerosis in mice by regulating actin skeleton in vascular smooth muscle cells].[J]. Nan fang yi ke da xue xue bao = Journal of Southern Medical University,2019,39(11).
3.中华医学会.《临床技术操作规范·病理学分册》.人民军医出版社,2004.